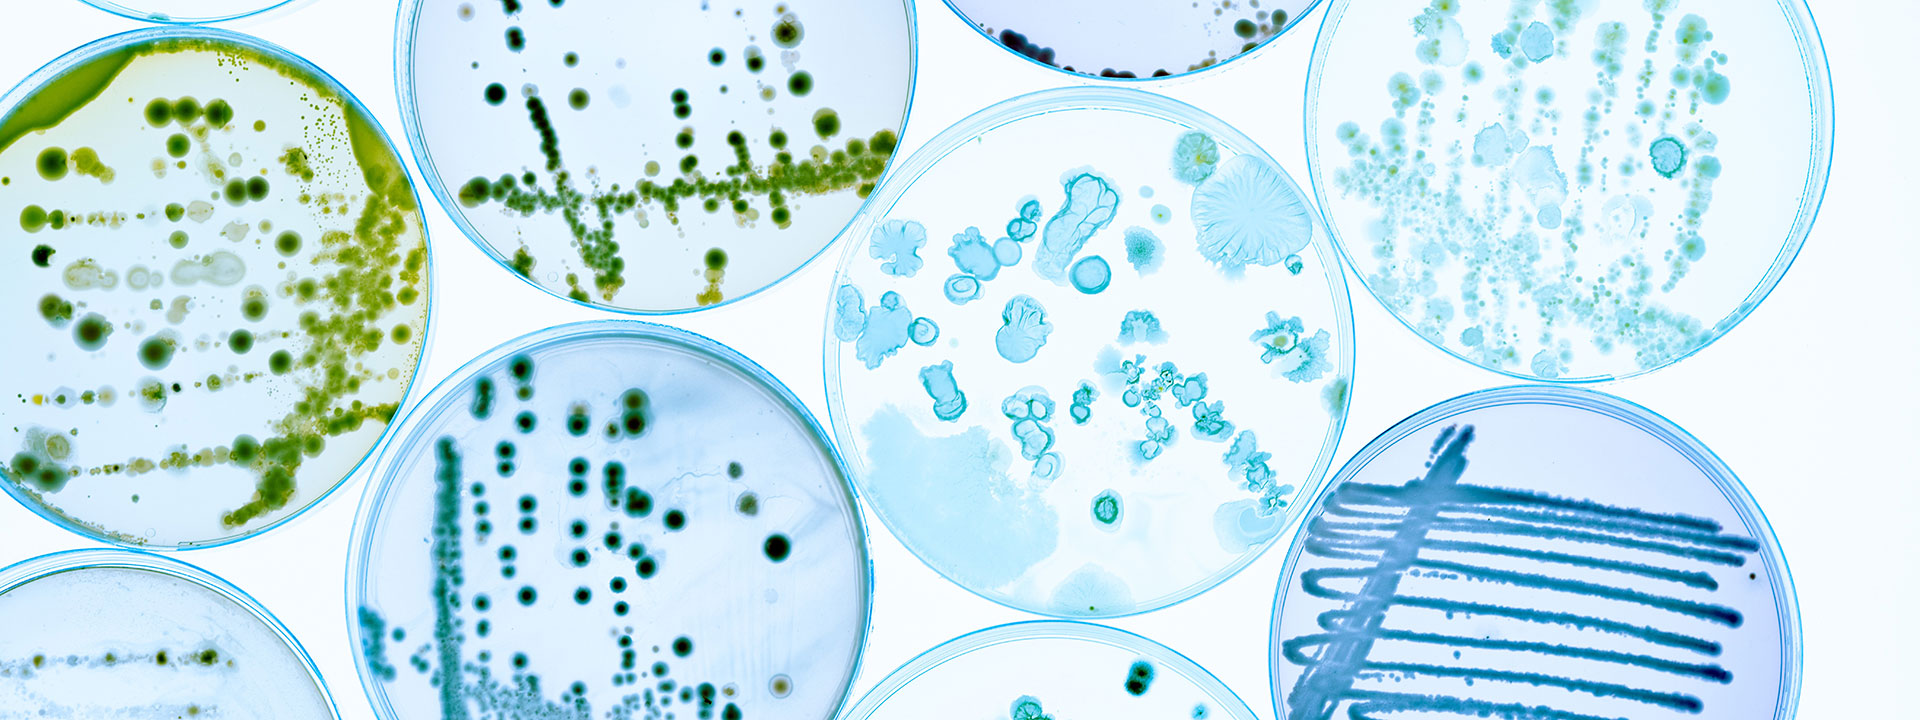
microbiology_banner_1920x720px

Microbiology testing
The Eurofins Food & Feed Testing laboratories offer a comprehensive range of microbiological testing services designed to help you verify food safety, meet regulatory requirements, and ensure the quality of your products.
Key services
- Pathogen detection of emerging pathogens and foodborne toxins, such as
- Listeria monocytogenes
- Salmonella species
- Legionella pneumophila
- Escherichia coli (E. coli) including O157
- Vibrio species
- Cronobacter (formerly Enterobacter) sakazakii
- Clostridium perfringens
- Bacillus cereus
- Campylobacter
- Enterotoxins
- Staphylococcus aureus
- Yersinia enterocolitica
- Food viruses
- Characterisation of micro-organisms (including the identification / characterisation of micro-organism strains)
- Food shelf-life studies or shelf-life determination including challenge testing
- Food spoilage investigation/explanation including through bacterial flora testing (NGS)
- Tracking pathogens contamination on site with whole genome sequencing (WGS)
- Rapid mould identification
- Hygiene parameters
- Expert advice to help you interpret results, support control plan development, and take informed action
Accredited microbiological testing with rapid turnaround
Our ISO 17025-accredited laboratories provide high-throughput testing with rapid turnaround times. We support manufacturers, retailers, and food service providers with expert microbiological analysis aligned with EU regulations, industry standards, and client-specific specifications.
Flexible testing methods to meet your requirements
Our comprehensive portfolio includes
- Standardised ISO and national reference methods
- Rapid, validated alternatives (e.g. PCR and chromogenic media) for negative pathogen detections; ideal for product release testing
Get in touch
Would you like to find out more about our testing solutions, or do you need tailored analytical support? Contact us today to get in touch with our experts.